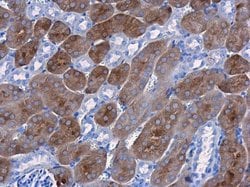
Invitrogen CBS Monoclonal Antibody (GT519) 100 &mu;L; Unconjugated:Antibodies,

missing translation for 'onlineSavingsMsg'
Learn More
Learn More
Invitrogen™ CBS Monoclonal Antibody (GT519)


Mouse Monoclonal Antibody
Brand: Invitrogen™ MA517273
This item is not returnable.
View return policy
Description
Recommended positive controls: HeLa, 293T, Raji, K562, mouse liver, rat liver. Predicted reactivity: Mouse (94%), Rat (94%), Xenopus laevis (93%), Rabbit (95%), Bovine (94%). Store product as a concentrated solution. Centrifuge briefly prior to opening the vial.
Only known pyridoxal phosphate-dependent enzyme that contains heme. Important regulator of hydrogen sulfide, especially in the brain, utilizing cysteine instead of serine to catalyze the formation of hydrogen sulfide. Hydrogen sulfide is a gastratransmitter with signaling and cytoprotective effects such as acting as a neuromodulator in the brain to protect neurons against hypoxic injury.
Specifications
| CBS | |
| Monoclonal | |
| 0.97 mg/mL | |
| PBS with no preservative | |
| P32232, P35520, Q91WT9 | |
| CBS | |
| Recombinant protein encompassing a sequence within the center region of human CBS. The exact sequence is proprietary. | |
| 100 μL | |
| Primary | |
| Human, Mouse, Rat | |
| Antibody | |
| IgG1 |
| Immunohistochemistry (Paraffin), Western Blot | |
| GT519 | |
| Unconjugated | |
| CBS | |
| AI047524; AI303044; Beta-thionase; Cbs; CBSL; cystathionine beta synthase; cystathionine beta-synthase; cystathionine beta-synthase; LOW QUALITY PROTEIN: cystathionine beta-synthase; Cystathionine beta-synthase-like protein; cystathionine-beta-synthase; hemoprotein H-450; HIP4; LOC100057612; methylcysteine synthase; serine sulfhydrase | |
| Mouse | |
| Protein G | |
| RUO | |
| 12411, 24250, 875 | |
| Store at 4°C short term. For long term storage, store at -20°C, avoiding freeze/thaw cycles. | |
| Liquid |
Berichtigung von Produktinhalten
Bitte geben Sie uns Ihr Feedback zu den Produktinhalten, indem Sie das folgende Formular ausfüllen.
Name des Produkts
Haben Sie Verbesserungsvorschläge?Übermitteln Sie eine inhaltliche Korrektur